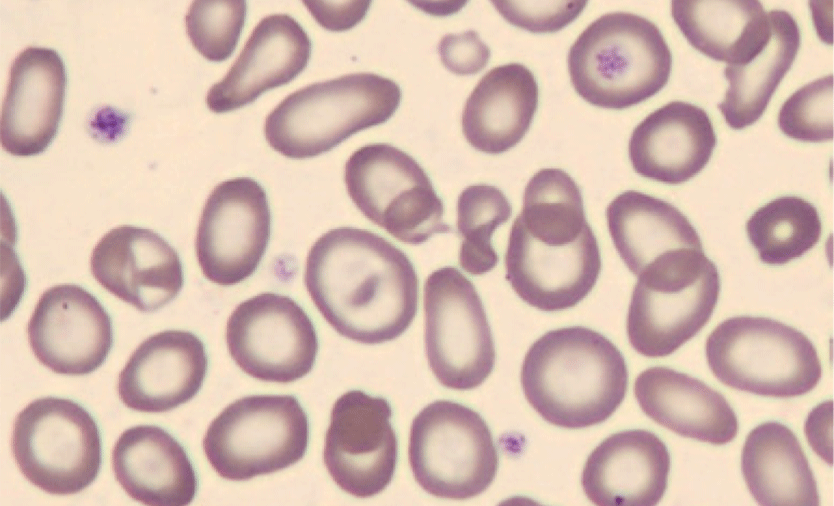
anemia image

La ciencia de Sysmex - Estudio de caso en hematología
Descargar PDF
La carencia de hierro es la causa más frecuente de anemia. Para determinar el estado del hierro de un paciente, se suelen utilizar los niveles bajos de hemoglobina y hematocrito, los índices de eritrocitos y los estudios del hierro. Este paciente adulto presenta microcitosis con un VCM de 54,9 fL. Los GR microcíticos interfieren con el histograma plaquetario de impedancia (PLT-I); esto ocasiona que el resultado del Volumen Plaquetario Medio (VPM) no sea notificable. Se obtuvo un recuento plaquetario preciso utilizando el canal de plaquetas fluorescentes (PLT-F) del analizador hematológico automatizado de la Serie-XN™. Cuando se utiliza el recuento del canal PLT-F, se enmascaran las
marcas de plaquetas generadas a partir del histograma de PLT-I.
Al paciente se le realizó un panel de reticulocitos completo que incluía el recuento de reticulocitos, la fracción de reticulocitos inmaduros (IRF) y el equivalente de hemoglobina reticulocitaria (RET-He). Aunque no se presenta reticulocitosis, que se esperaría en respuesta a un estado ferropénico, la IRF se encuentra elevada, lo que indica que la médula ósea está produciendo activamente reticulocitos jóvenes. El RET-He de 17,9 pg es extremadamente bajo, lo que demuestra que los reticulocitos recién producidos presentan un nivel reducido de hemoglobina. Esto es preocupante porque los reticulocitos hipocrómicos se convertirán en eritrocitos hipocrómicos con una capacidad de transporte de oxígeno deficiente (o disminuida) en comparación con los eritrocitos normocíticos. En consecuencia, el paciente puede sentirse aletargado y presentar dificultades para llevar a cabo sus actividades cotidianas.
Sigue leyendo Descargar PDF
